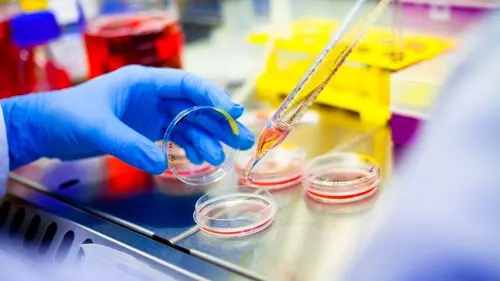
48 heures pour un crime : interrogatoires S01E13 L'ADN a parlé

Comment supprimer la publicité ?
TV-PROGRAMME.COM nécessite une équipe complète pour fonctionner, évoluer et rester gratuit pour tous.
La publicité contribue aujourd’hui à financer ce service et à rémunérer les personnes qui le font vivre.
En vous abonnant, vous profitez du service sans publicité tout en soutenant plus directement TV-PROGRAMME.COM.
Je supprime la publicitéDes policiers impliqués reviennent témoigner et faire le point sur des affaires toujours en cours.
Vidéo Programme TV ce soir
Comment supprimer la publicité ?
TV-PROGRAMME.COM nécessite une équipe complète pour fonctionner, évoluer et rester gratuit pour tous.
La publicité contribue aujourd’hui à financer ce service et à rémunérer les personnes qui le font vivre.
En vous abonnant, vous profitez du service sans publicité tout en soutenant plus directement TV-PROGRAMME.COM.
Je supprime la publicité